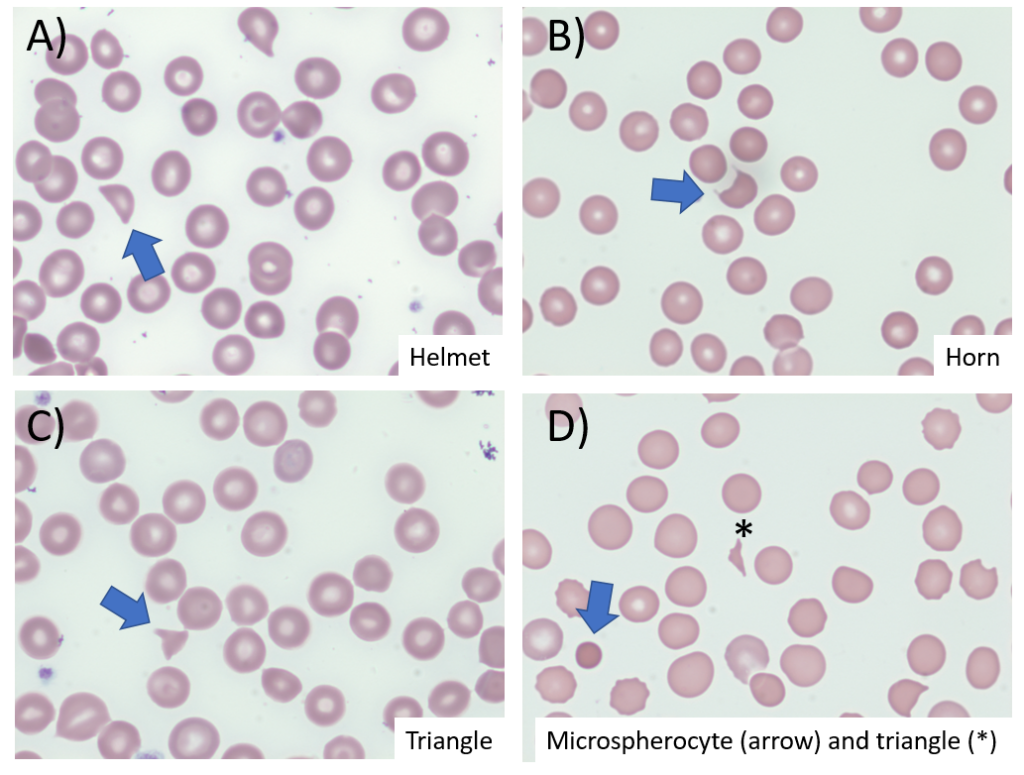

Schistocytes
What are schistocytes?
- Schistocytes are circulating fragments of red blood cells or RBCs from which cytoplasmic fragments have been lost, suggestive of:
- Thrombotic microangiopathy
- Malfunctioning prosthetic valve
- Schistocytes are always smaller than intact red cells and may be recognized as:
- Triangles
- Small crescents
- Helmet cells
- Keratocytes (horn cells)
- Microspherocytes
- Schistocytes are homogeneously stained in most cases with the exception of keratocytes, which may have some central pallor.
- RBC fragments similar to schistocytes can be found in non-TMA-related genetic or acquired RBC disorders:
- Including:
- Red blood cell membrane defects
- Thalassemia
- Megaloblastic anemia
- Primary myelofibrosis
- Thermal injuries
- Typically show highly variable shapes and are associated with marked anisopoikilocytosis and a wide range of additional RBC size and morphological changes.
- Including:
- Schistocytes are detected in the peripheral blood smear stained using standard procedures and observed by light microscopy, and expressed as a percentage of RBCs.
- Precise morphological criteria for the recognition and enumeration of schistocytes still remain poorly defined, leading to observer bias.
- A schistocyte count should be considered clinically meaningful if they represent the main morphological red blood cells abnormality in the smear (other than signs of erythropoietic regeneration).
- The univocal mechanism of schistocyte formation is mechanical damage to the membrane caused by fibrin strands on the endothelial surface and/or excess of turbulence of blood. They develop because red blood cells are sheared as they try to pass through small vessels narrowed by microthrombi.
The following are examples of 4 of the 5 schistocyte types recognized by the Schistocyte Working Group of the International Council for Standardization in Haematology (ICSH):
The presence of schistocytes helps to narrow the differential diagnosis to a thrombotic microangiopathy (TMA), including thrombotic thrombocytopenia purpura (TTP), hemolytic uremic syndrome (HUS) or disseminated intravascular coagulation (DIC).
Can the number/frequency of schistocytes help make a diagnosis of TMA?
- Schistocyte count is up to 0.2% in normal individuals.
- In DIC, the schistocyte count is typically between 0.2% and 1%. However, counts can exceed 1%.
- In TTP and HUS:
- A robust morphological indication for the diagnosis of thrombotic microangiopathic anemia in adults should be recognized when the percentage of schistocytes is above 1%. However, a lack of schistocytes does not exclude a priori the diagnosis of TMA (learn more here). There is no threshold schistocyte number below which the possibility of TTP can be excluded.
- In the appropriate clinical context, more than two schistocytes per high-powered field or more than 1.0% schistocytes on a blood film is considered pathologic; however, these cut-offs have not been validated (learn more here).
The following are results from a a cohort of 46 patients with TTP and severe ADAMTS13 deficiency. Note the wide variation in schistocyte counts:

Bottom line:
A high number of schistocytes on the peripheral smear suggests a diagnosis of thrombotic microangiopathy (TMA), but cannot reliably distinguish between TTP and other types of TMA.